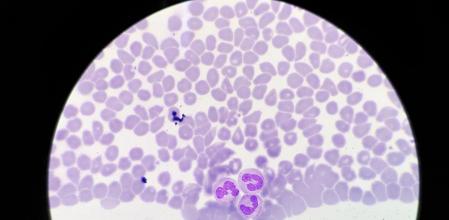
Horizontal

El síndrome de Felty es una enfermedad muy rara en la que se combinan diversos factores como neutropenia, artritis reumatoide e inflamación del bazo.
Causas del síndrome de Felty
No se conoce la causa exacta
La causa del síndrome de Felty se desconoce. Es un hecho que se da con más frecuencia en enfermos que han sufrido artritis reumatoide (AR) durante un largo periodo de tiempo. Una de las consecuencias del síndrome de Felty es la disminución del número de glóbulos blancos lo que implica que hay un riesgo grande de contraer infecciones.
Síntomas del síndrome de Felty
Sintomatología diversa
El síndrome de Felty presenta síntomas bastante diversos como:
- Malestar.
- Dolor muscular.
- Picor en el ojo.
- Sensación de cansancio.
- Ausencias de ganas de comer.
- Palidez.
- Dolor en las articulaciones.
- Frecuentes infecciones
Diagnóstico del síndrome de Felty
Análisis de sangre y observación
El médico realiza un examen visual para determinar los síntomas y poder demostrar o descartar la posibilidad del síndrome de Felty. Concretamente, los síntomas más claros que querrá confirmar son la inflamación del bazo y la presencia de indicadores de la artritis reumatoide.
El análisis de sangre revelará si hay pérdida de glóbulos blancos y una prueba de diagnóstico por imagen ha de revelar si efectivamente el bazo se ha hinchado, de la misma manera que otros órganos como el hígado. También pueden aparecer ganglios linfáticos.
Tratamiento y medicación del síndrome de Felty
Lucha contra la artritis reumatoide
Dado que el síndrome de Felty está relacionado con la artritis reumatoide, el tratamiento inicial debe ser el de combatir esta enfermedad. Al mismo tiempo debe suministrarse una medicación para mejorar la producción de glóbulos blancos. Por último, en ciertos casos, lo aconsejable es la extirpación del bazo.
Prevención del síndrome de Felty
Evitar la artritis reumatoide
La prevención debe venir por la vía de combatir la artritis reumatoide y de esta manera reducir el riesgo de la aparición del síndrome de Felty. Las medidas básicas son: seguir una dieta sana y equilibrada, combatir el sobrepeso o la obesidad y fortalecer la musculatura que rodea las articulaciones.